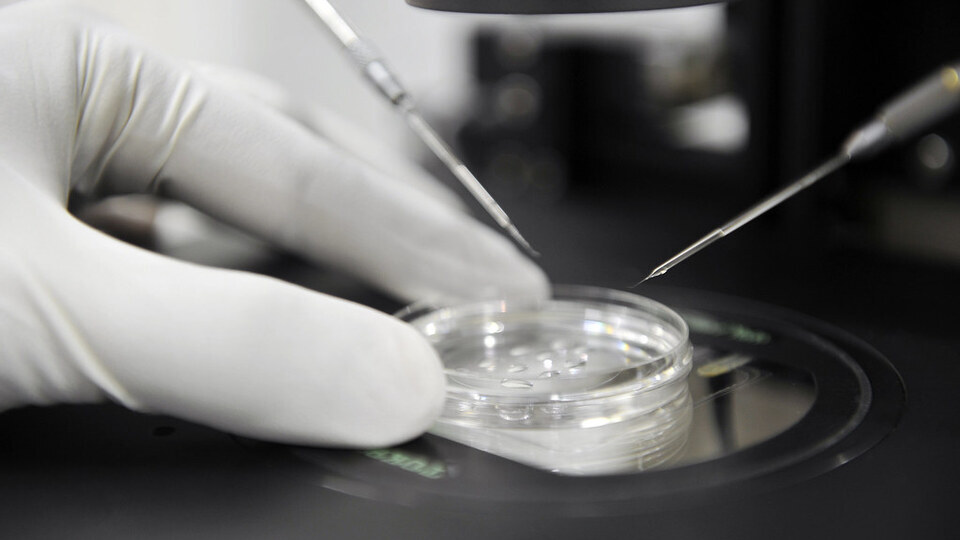

Kandydat KO na prezydenta miasta proponuje… bony na in vitro
Na poniedziałkowej konferencji prasowej w Kaliszu kandydat KO na prezydenta powiedział, że miasto powinno wspierać pary uczestniczące w metodzie leczenia bezpłodności. W tym celu proponuje wprowadzenie bonów wspierających procedurę in vitro.
"Takie wsparcie ze strony miasta byłoby bardzo potrzebne. Żeby uczestniczyć w programie, trzeba pojechać na badania, a nie każdego na to stać"
- powiedział.
Czytaj także: Są nowe informacje ws. zabójstwa 82-latka z Przasnysza
Propozycje Łuszczykiewicza
Miasto - jak poinformował - powinno też realizować programy profilaktyczne dotyczące mammografii dla kobiet młodych i bardzo młodych. "Choroby nowotworowe, w tym rak piersi, dotykają również młode panie" - powiedział.
Zdaniem Łuszczykiewicza w urzędzie miasta należy powołać pełnomocnika ds. równych szans. Jego zadaniem - wskazał - byłoby egzekwowanie praw kobiet i przeciwdziałanie przemocy wobec kobiet.
Obecny na konferencji poseł KO Mariusz Witczak powiedział, że obecny prezydent Kalisza, mimo wniosków ze strony niektórych radnych, nie podjął decyzji o dofinansowaniu leczenia metodą in vitro.
Autorem interpelacji w tej sprawie był radny KO Marcin Małecki. "Apelowałem do prezydenta o uruchomienie miejskiego programu, który funkcjonuje w dużo mniejszych miastach Wielkopolski. Zawsze padała odpowiedź, że nie ma na to pieniędzy" - powiedział.
Czytaj także: Ujawniono słowa Tuska: "Jeśli do władzy wróci PiS, wszyscy pójdziemy siedzieć"
Kontekst: zmiany w prawie
Witczak przypomniał, że rocznie z budżetu państwa będzie przeznaczane co najmniej 500 mln zł na finansowanie leczenia niepłodności metodą in vitro, a program ma ruszyć od 1 czerwca 2024 r.
"Udało nam się też uchwalić z inicjatywy Koalicji Obywatelskiej ustawę o antykoncepcyjnej pigułce dzień po. Donald Tusk podjął decyzję i wydał zalecenie Prokuratorowi Generalnemu i Ministrowi Zdrowia w dwóch kwestiach, które za rządów PiS -u kojarzyły się z tragediami. Jeżeli lekarz w krytycznych przypadkach będzie miał jakikolwiek dylemat czy ratować życie kobiety czy nie, to będzie ścigany z urzędu przez Prokuratora Generalnego. Minister Zdrowia wydał zalecenia, że w szpitale, w których lekarz będzie zasłaniał się klauzulą sumienia, będą traciły kontrakty na ginekologię"
- powiedział poseł.
Komentarze
W służbie zdrowia zapaść, a MZ przeznaczy dodatkowe 100 mln zł na in vitro

Przed nami XXXIII Ogólnopolska Pielgrzymka Robotników i Pracodawców do św. Józefa w Kaliszu
Niebezpieczny incydent pod Kaliszem. Pocisk wpadł do mieszkania
Ekipa Tuska wyda potężne pieniądze żeby kolej dużych prędkości ominęła aglomerację kalisko-ostrowską
Ważna informacja dla mieszkańców Kalisza



